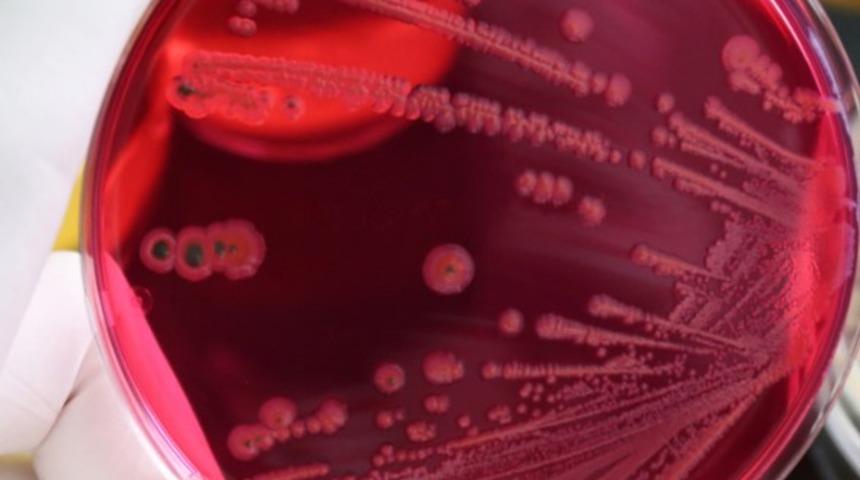
Yazın artan besin zehirlenmelerine dikkat

Yazın en güzel yanlarından biri de meyve ve sebze çeşitliliğinin artması. Yaz mevsimiyle birlikte sofralarda daha çok taze sebze ve meyveye yer veriliyor. Ancak havaların ısınması aynı zamanda besin kaynaklı zehirlenmelerin görülme sıklığını da artırıyor. Taze ürünler gerekli kurallara dikkat edilmediğinde besin kaynaklı hastalıklara neden olabileceğinden besin hijyenine çok dikkat etmek gerekiyor. Örneğin, et doğradığınız bir bıçağı ve aynı kesme tahtasını yıkamadan sebzeleri doğramak besin zehirlenmelerine neden olabilecek mikroorganizmaların çiğ tüketilen salatanıza geçmesine neden olabiliyor. Taze meyve ve sebzeler açısından zengin bir diyet, sağlığın korunması için gerekli vitamin, mineral ve lifi sağlamak için olmazsa olmaz. Temel hijyen kurallarına uyulması, taze sebze ve meyve kaynaklı besin zehirlenmelerinin önüne geçmekte oldukça etkili bir korunma sağlıyor.
Uzmanlar, besin kaynaklı zehirlenme riskini azaltmak için alınması gereken basit önlemleri paylaştı:
Alışveriş yaparken taze görünen ve iyi durumda olan meyve ve sebzeleri seçin. Kötü kokulu, gözle görünür şekilde hasar görmüş veya küflü besinlerden kaçının.
Sadece ihtiyacınız olan miktarda ürün satın alın ve tazeyken tüketmeye özen gösterin.
Bazı meyve ve sebzeler uzun süre bozulmadan saklanabilir ancak besin değerlerinin korunması için çoğu besini birkaç gün içerisinde tüketmek gerekiyor.
Ürünleri eve getirdiğinizde bekletmeden soğuk (5°) bir buzdolabına koyun.
Daha fazla olgunlaşma gerektiren muz, domates veya meyveler oda sıcaklığında tutulabilir.
Yemeden önce meyve ve sebzeleri akan suyun altında yıkayın. Dış yaprakları veya kabukları soyun. Kabuklarıyla tüketmek istiyorsanız sebzelerin ve meyvelerin dış yüzeylerini akan suyun altında iyice ovalayın.
Kavun, karpuz veya elma gibi sert yüzeyli sebze ve meyveler için sebze fırçası kullanın. Küçük ve daha hassas meyveler için bir kevgir kullanarak, zarar görmelerini en aza indirin. Kapsamlı şekilde iyi bir yıkama, yüzeyde kalan zararlı bakterileri, virüsleri ve kalıntıları gidermek için yeterli oluyor.
Özellikle taze et/balık/tavuk gibi ürünlerde pişirmeden önce kullanacağınız yüzeyleri, aletleri ve ellerinizi temizlediğinizden emin olun. Çapraz bulaşı önlemek için çiğ ürünleri doğradığınız tahta ve bıçağı diğer bir besin için kullanmadan mutlaka iyice yıkayın.
Hazırlanan meyve salatalarını ve diğer kesilmiş ürünleri servis edilene kadar buzdolabında saklayın. Dört saatten fazla buzdolabı dışında bekleyen besinleri tüketmeyin.